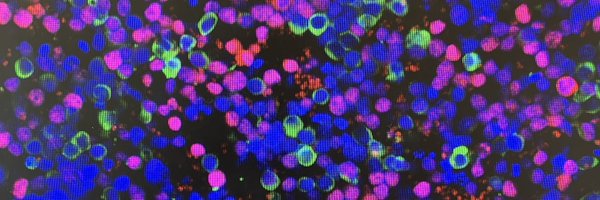
manas_adriana Profile Banner

Adriana Mañas
@manas_adriana
Followers
1K
Following
30K
Media
783
Statuses
7K
PhD Cell & Molecular Biology - Pediatric Cancer Research; Miguel Servet Principal Investigator at @idipazscience - Científica repatriada 🇪🇸🇺🇸🇸🇪
Joined May 2019
Un año más se han otorgado los premios @IgNobel (los premios científicos más geniales que hay!). Se dan a descubrimientos/investigaciones que primero te hacen reír y luego te hacen pensar! 😁 Aquí van los ganadores de este año 👇🧵
4
180
427
Una terapia CAR-T salva por primera vez en el mundo a una niña con una enfermedad autoinmune rara en el Hospital de La Paz https://t.co/xS984cVBrD via @el_pais
elpais.com
Una exitosa colaboración entre hospitales públicos emplea una terapia celular desarrollada en España que se suele utilizar contra el cáncer
0
31
74
🔴 ¡Hasta aquí el #DíaCienciaCRIS25! Como cada año, esta ceremonia representa un momento lleno de emoción, donde celebramos la dedicación de todos los investigadores que hacen que avancemos hacia un futuro libre de cáncer. 💪🏼💛 ¡Gracias a todos y a todas por hacerlo posible!👏🏼
0
7
21
Today is my last day as a MSCA postdoc fellow! 🥳 I am super happy to announce that on Monday I will start a new adventure as a tenure-track “Miguel Servet” funded principal investigator at @IdiPAZScience I will continue to work on advancing treatment for pediatric solid tumors
6
2
29
Big news: we are setting up a new non-profit organization to run bioRxiv and medRxiv. It's called openRxiv [no it's not a new preprint server; it's a dedicated organization to oversee the servers] https://t.co/4siujZbXxF 1/n
openrxiv.org
openRxiv is an independent non-profit, the new organizational home for bioRxiv and medRxiv, enabling researchers to instantly share groundbreaking findings with the global scientific community.
11
176
510
Una transfusión de sangre le salvó la vida a los 14 años Años después, los médicos descubrieron que su sangre tenía algo único: - Podía salvar a bebés de una enfermedad mortal - Donó sangre casi todas las semanas durante 60 años - Salvó más de 2,4 millones de vidas Pero lo más
246
9K
49K
Nueva tendencia en Instagram: hospitales y residencias de ancianos en Alemania muestran cómo dependen de los inmigrantes que trabajan, cómo son parte del país, amigos, colegas. “Seríamos más pobres sin ellos. Se los aprecia. Son nosotros.”
2K
18K
100K
So proud of our future PhD Carmen Mestre-Durán @L4CLaPaz @CNIOStopCancer @criscancer presenting Alloreactive versus il-15 ex-vivo-stimulated NK cells - Carmen Mestre-Durán 🔗 https://t.co/uqJBf2Cv6Q at #ICLE2025 learning from the best @fredhutch @carlhjune next step @TheEBMT
0
2
14
Según la misma vecina, @BeefciousBurger de #ElCañaveral, hace lo mismo con líquido desengrasante cuando limpian la puerta de cocina y acera. Asegura que se han repuesto los árboles en varias ocasiones debido a los daños. Se notificará también a @MADRID.
Algo que no me gusta de @LPecoranera de #ElCañaveral 😒 El vertido de agua con jabón, de fregar los suelos, en los alcorques frente a la puerta de cocina. Ayer una vecina decía que ya se lo echó en cara y no hicieron caso. Se notificará a @MADRID. No sobran árboles... #AsíNo
7
7
14
Hey! @elonmusk your doge minions just fired me and my colleagues at CMMI. We were working on improving maternal health outcomes AT LOWER COSTS so that less pregnant women would die in this county. I thought that would fit nicely into your agenda?
16K
30K
261K
Es increíble la de gente que dice estar “silenciada” pero luego está en televisión, periódicos y radios constantemente. Es una cosa fina 😅
7
47
302
Roses are red Violets are blue You need a PhD supervisor Who cares about you
10
188
1K
El #cáncerpediátrico es distinto del de los adultos y requiere investigación y terapias específicas. En el #DíaInternacionaldelCáncerInfantil presentamos cómo el #CNIOStopCancer busca inmunoterapias más efectivas y con menos efectos secundarios para niños y niñas con cáncer.
1
6
7
Si nos quejáramos igual por los recortes en sanidad, en educación o por no poder pagar una vivienda que por un estadio de fútbol, quizás nos iría un poquito mejor. Pero claro, eso no se puede gritar en los bares. 🍻⚽ #Prioridades
📸🎥 Así fue la noche de tensión en Nájera: concejales escoltados, enfado ciudadano e intervención de la Guardia Civil
6
6
33
@javidearnedo Una de las cosas que más me preocupan como científica es que los sueldos de los investigadores predoctorales ya son el SMI. Personal altamente cualificado desarrollando actividad muy específica, cobrando el SMI. Está genial subir el SMI, pero estaría bien revisar otras cosas.
4
11
43
¿Por qué se invita a influencers totalmente ajenos al mundo del cine a la entrega de premios mientras se aparta a otros colectivos como iluminación, guionistas, maquilladores, sonidistas…? #Goya2025
84
663
6K
❌ No, la Comisión Europea no interfiere en las elecciones nacionales. Estas se rigen por normas y procedimientos de los que es responsable cada Estado miembro. ✅Sí, las elecciones libres y justas son la piedra angular de nuestras democracias. Y queremos que sigan siéndolo.
39
75
159
¿Tienes más de un 8 de expediente en el grado? ¿Estás haciendo el máster? Si quieres hacer la tesis en biomedicina, para estudiar como la #autofagia modula el sistema inmune, contáctame para pedir becas predoc (FPU, USAL…) Escríbe: marinagarciamacia@usal.es #Salamanca #Ciencia
0
20
22
BERNIE SANDERS: Vaccines do not cause autism. Do you agree? RFK Jr: As I said, I'm not going into HHS with any preordained-- SANDERS: I asked you a simple question, Bobby RFK Jr: If you show me those studies ... SANDERS: That is a very troubling response
3K
15K
218K